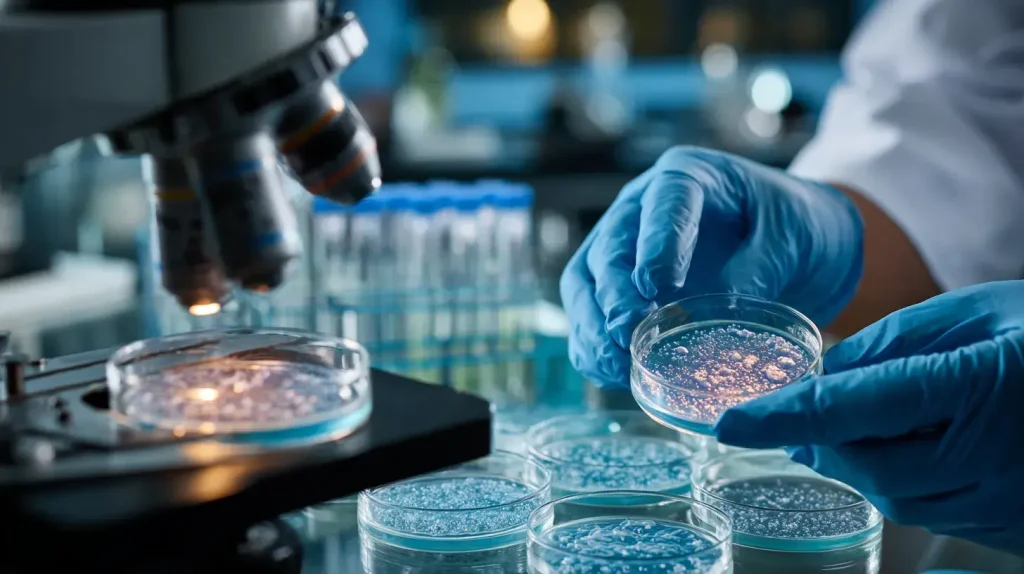
vitamine D cheveux et peau

Introduction
Chute de cheveux diffuse, cheveux fins qui ne repoussent plus, ralentissement visible de la pousse : ces symptômes capillaires peuvent révéler un déséquilibre nutritionnel profond. Parmi les carences fréquemment identifiées, celle en vitamine D attire l’attention des dermatologues et des chercheurs. Cette vitamine, souvent associée à la santé osseuse et immunitaire, joue également un rôle dans le cycle de vie du follicule pileux. Comprendre ce lien permet d’identifier si une supplémentation peut réellement améliorer la santé capillaire et dans quelles conditions.
La vitamine D : bien plus qu’une vitamine pour les os
La vitamine D agit comme une hormone qui régule l’expression de centaines de gènes. Son rôle dépasse largement la simple régulation du calcium et du phosphore : elle soutient le système immunitaire, module l’inflammation et influence la différenciation cellulaire dans de nombreux tissus.
Notre organisme produit de la vitamine D principalement par synthèse cutanée lors de l’exposition aux UVB. Cette production solaire représente 80 à 90 % des apports chez une personne qui s’expose régulièrement. Les sources alimentaires restent limitées : poissons gras (saumon, maquereau, sardines), œufs, foie, et certains produits enrichis. Face à ces apports souvent insuffisants, les compléments alimentaires deviennent une option courante.
La prévalence de la carence inquiète : 40 à 50 % de la population française présente une insuffisance, avec un taux sanguin inférieur à 30 ng/ml. Cette situation s’aggrave particulièrement en hiver, chez les personnes à peau foncée (dont la mélanine freine la synthèse cutanée), les personnes âgées (dont la peau produit moins efficacement la vitamine D), et toutes celles qui s’exposent peu au soleil.
Le cycle de vie du cheveu : rappel des phases essentielles

Pour comprendre l’impact de la vitamine D, il faut d’abord saisir le fonctionnement du follicule pileux. Chaque cheveu traverse trois phases distinctes dans un cycle continu.
- La phase anagène dure de 2 à 7 ans selon les individus. C’est la période de croissance active durant laquelle le cheveu s’allonge. Normalement, 85 à 90 % de vos cheveux se trouvent dans cette phase à un moment donné. La durée de cette phase détermine la longueur maximale que peuvent atteindre vos cheveux.
- La phase catagène ne dure que 2 à 3 semaines. Le follicule se rétracte, le cheveu cesse de pousser. Cette phase de transition prépare l’élimination naturelle du cheveu.
- La phase télogène s’étend sur 2 à 4 mois. Le cheveu reste attaché mais ne pousse plus, puis tombe naturellement pour laisser place à un nouveau cheveu qui commence déjà à pousser en dessous, repoussant l’ancien.
Perdre 50 à 100 cheveux par jour reste parfaitement physiologique. Mais une perturbation du cycle peut faire basculer trop de cheveux simultanément en phase télogène, provoquant une chute diffuse visible et parfois inquiétante. C’est précisément ce qui peut survenir en cas de carence nutritionnelle.
Vitamine D et follicule pileux : ce que dit la recherche scientifique

Le lien entre vitamine D et cheveux ne relève pas de la simple spéculation. Le follicule pileux possède des récepteurs VDR (Vitamin D Receptor) qui permettent à la vitamine D d’agir directement sur les cellules du follicule. Cette présence de récepteurs spécifiques indique un rôle physiologique réel.
La vitamine D régule la différenciation des cellules souches qui donnent naissance aux nouvelles cellules du cheveu. Ces cellules souches, situées dans le bulge du follicule, représentent le réservoir à partir duquel chaque nouveau cheveu se forme. Sans vitamine D fonctionnelle, ce processus de différenciation se dérègle et la production de nouveaux cheveux s’en trouve affectée.
Les études sur modèles animaux apportent des preuves convaincantes. Les souris génétiquement modifiées sans récepteur VDR développent une alopécie totale, démontrant le rôle crucial de la vitamine D dans le maintien du follicule. Bien que les mécanismes chez l’humain soient plus complexes, ces modèles confirment l’importance biologique de cette vitamine pour le cycle capillaire.
Chez l’humain, plusieurs études cliniques observent une corrélation entre taux bas de vitamine D et chute de cheveux. Cette association apparaît particulièrement marquée dans deux situations : l’alopécie areata (apparition de plaques sans cheveux) et l’effluvium télogène (chute diffuse et brutale). Ces observations ne prouvent pas systématiquement un lien de causalité direct, mais justifient l’attention portée au statut vitaminique D en cas de troubles capillaires.
Carence en vitamine D : un facteur de chute de cheveux

Une carence en vitamine D perturbe le cycle de croissance du cheveu selon plusieurs mécanismes. Elle raccourcit la phase anagène et provoque un passage prématuré en phase télogène. Résultat : des cheveux qui poussent moins longtemps et tombent plus vite, sans avoir atteint leur longueur maximale. La densité capillaire diminue progressivement et la repousse devient moins vigoureuse.
Cette carence se manifeste à travers différents types de chute. L’effluvium télogène provoque une chute diffuse et souvent brutale : les cheveux tombent en quantité inhabituelle sur l’ensemble du cuir chevelu. L’alopécie areata se caractérise par l’apparition de plaques circulaires dépourvues de cheveux. Enfin, certaines personnes constatent un amincissement général de leur chevelure sans cause apparente, avec des cheveux qui deviennent progressivement plus fins et moins nombreux.
Attention toutefois : la vitamine D n’est jamais seule en cause. Les carences en fer, zinc ou biotine peuvent produire des symptômes similaires. Les troubles hormonaux (dysfonctionnement thyroïdien, déséquilibre androgénique), le stress chronique, et certaines maladies auto-immunes provoquent également des chutes de cheveux. Un diagnostic rigoureux s’impose pour identifier précisément l’origine du problème.
Corriger une carence en vitamine D peut-il stopper la chute de cheveux ?

La question mérite une réponse nuancée. Les études montrent que la correction d’une carence démontrée améliore la repousse chez certaines personnes, particulièrement en cas d’effluvium télogène lié à une carence sévère. L’amélioration ne survient pas chez tous les patients, mais les résultats s’avèrent encourageants lorsque la carence constitue réellement un facteur contributif.
La repousse des cheveux prend du temps. Il faut compter 3 à 6 mois de supplémentation régulière pour observer une amélioration visible. Ce délai correspond au temps nécessaire pour que le cycle capillaire se stabilise : les cheveux actuellement en phase télogène doivent tomber, puis de nouveaux cheveux doivent entrer en phase anagène et pousser suffisamment pour devenir visibles. La patience reste indispensable.
Les limites de la supplémentation méritent d’être soulignées. Si la chute n’est pas liée à une carence en vitamine D, la supplémentation n’aura pas d’effet notable sur les cheveux. Prendre de la vitamine D sans carence avérée ne stimulera pas magiquement la pousse capillaire. Un bilan sanguin s’impose avant toute supplémentation pour éviter de perdre du temps et de l’argent dans une démarche inefficace.
Faut-il doser sa vitamine D avant de se supplémenter ?

Le dosage sanguin de la 25-OH vitamine D (forme de stockage) permet de confirmer ou d’exclure une carence. Se supplémenter sans savoir si on est carencé expose à un surdosage inutile et empêche d’identifier la véritable cause des symptômes. Ce dosage simple guide ensuite le choix du dosage approprié.
Les valeurs de référence établissent plusieurs catégories. Une carence sévère se situe en dessous de 10 ng/ml et nécessite une correction rapide. L’insuffisance concerne les taux entre 10 et 30 ng/ml. Le niveau optimal se situe entre 30 et 50 ng/ml, fourchette recommandée par la plupart des experts pour une santé optimale. Au-delà de 100 ng/ml, on entre dans une zone d’excès potentiellement toxique.
Certaines personnes devraient systématiquement vérifier leur taux : celles qui présentent une chute de cheveux inexpliquée, celles peu exposées au soleil (travail en intérieur, mode de vie sédentaire), les personnes à peau foncée vivant en zone peu ensoleillée (la mélanine freine considérablement la synthèse cutanée), les personnes âgées (dont la capacité de synthèse diminue), et les femmes ménopausées (période où les changements hormonaux peuvent aussi affecter le statut vitaminique).
Optimiser naturellement son taux de vitamine D

L’exposition solaire reste la source la plus efficace. Exposez quotidiennement votre visage, vos bras et vos jambes pendant 10 à 30 minutes entre 11h et 15h, sans écran solaire. La durée dépend de votre phototype : les peaux claires produisent rapidement de la vitamine D, les peaux foncées nécessitent une exposition plus longue. Adaptez selon la latitude et la saison.
Les sources alimentaires méritent d’être privilégiées malgré leurs apports limités. Les poissons gras (saumon, maquereau, sardines) arrivent en tête, suivis du foie de morue (très riche mais peu consommé), du jaune d’œuf, et des champignons exposés aux UV. Certains produits enrichis (lait, céréales) apportent un complément. Ces apports alimentaires restent cependant rarement suffisants pour couvrir les besoins, surtout en hiver.
Les limites de l’exposition solaire selon les saisons posent problème en France métropolitaine. Entre octobre et mars, l’angle du soleil ne permet pas une synthèse suffisante de vitamine D, même par temps ensoleillé. Les UVB nécessaires à la production ne traversent pas l’atmosphère avec une intensité suffisante. Une supplémentation hivernale devient alors souvent nécessaire pour maintenir des taux optimaux.
Autres nutriments importants pour la santé des cheveux

Le fer assure l’oxygénation du follicule. Une carence en fer signifie un manque d’oxygénation des cellules du follicule, qui fonctionnent alors au ralenti. Cette carence provoque une chute diffuse, des cheveux fins et fragiles qui cassent facilement. Un bilan martial (dosage de la ferritine) s’avère indispensable en cas de chute, particulièrement chez les femmes en âge de procréer.
Le zinc participe à la synthèse de la kératine, protéine structurelle qui compose 95 % du cheveu. Une carence en zinc produit des cheveux cassants, ternes, et ralentit considérablement la pousse. Ce minéral intervient aussi dans la division cellulaire au niveau du follicule.
La biotine (vitamine B8) joue un rôle dans le métabolisme énergétique des cellules du follicule. Une carence reste rare dans l’alimentation normale, mais peut affecter la qualité du cheveu lorsqu’elle survient. La supplémentation en biotine montre des résultats mitigés : efficace uniquement en cas de carence avérée.
Les protéines et acides aminés soufrés constituent la matière première du cheveu. La kératine capillaire est particulièrement riche en cystéine, acide aminé soufré. Un apport protéique insuffisant (régimes restrictifs, alimentation déséquilibrée) affecte directement la structure et la croissance du cheveu.
Conclusion
La vitamine D joue un rôle réel dans la santé capillaire, confirmé par la présence de récepteurs spécifiques dans le follicule pileux et par les études scientifiques sur les modèles animaux et humains. Une carence sévère peut effectivement contribuer à une chute de cheveux, particulièrement dans les cas d’effluvium télogène ou d’alopécie areata.
Corriger cette carence par une supplémentation adaptée peut améliorer la repousse, mais uniquement si la carence était réellement présente et impliquée dans la chute. Un dosage sanguin préalable reste indispensable pour éviter une supplémentation inutile et guider le choix du protocole.
Sources :




Rejoindre la discussion
A propos de l'auteur
Simon de Nutriforce
Articles qui pourraient vous intéresser :
Les meilleurs compléments pour la concentration et la productivité
Comment utiliser le Shilajit ? Nos conseils pour une utilisation optimale
Testostérone en vente libre : Laquelle choisir ?